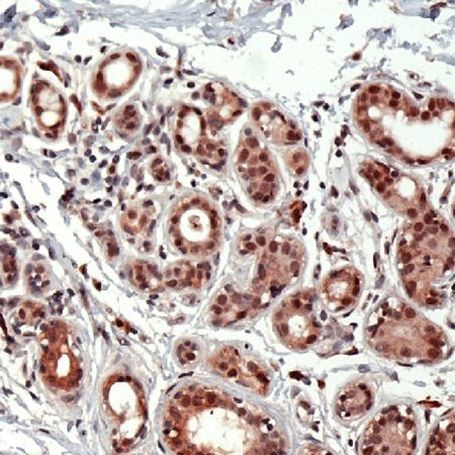
ID2 Antibody in Immunohistochemistry (IHC)

Search
Invitrogen
ID2 Polyclonal Antibody
{{$productOrderCtrl.translations['antibody.pdp.commerceCard.promotion.promotions']}}
{{$productOrderCtrl.translations['antibody.pdp.commerceCard.promotion.viewpromo']}}
{{$productOrderCtrl.translations['antibody.pdp.commerceCard.promotion.promocode']}}: {{promo.promoCode}} {{promo.promoTitle}} {{promo.promoDescription}}. {{$productOrderCtrl.translations['antibody.pdp.commerceCard.promotion.learnmore']}}
产品信息
PA5-32449
宿主/亚型
分类
类型
抗原
偶联物
形式
保存条件
运输条件
RRID
产品详细信息
Heat-mediated antigen retrieval is recommended prior to staining, using a 10mM citrate buffer, pH 6.0, for 10 minutes followed by cooling at room temperature for 20 min. Following antigen retrieval, incubate samples with primary antibody for 30 min at room temperature. A suggested positive control is breast carcinoma.
靶标信息
The inhibitor of DNA binding 2 (ID2) protein is essential for promoting the development of a number of cell types including natural killer cell, erythroid precursors, as well as, CD8+ and CD4+ T-cell. A lack of ID2 promotes B-cell development. The chief role of this protein is to associate with ubiquitously-expressed E proteins, and other proteins of the basic helix-loop-helix (HLH) family, preventing them from binding to DNA and activating transcription. Activation of ID2 is critical for the development of the natural killer cell lineage.
仅用于科研。不用于诊断过程。未经明确授权不得转售。